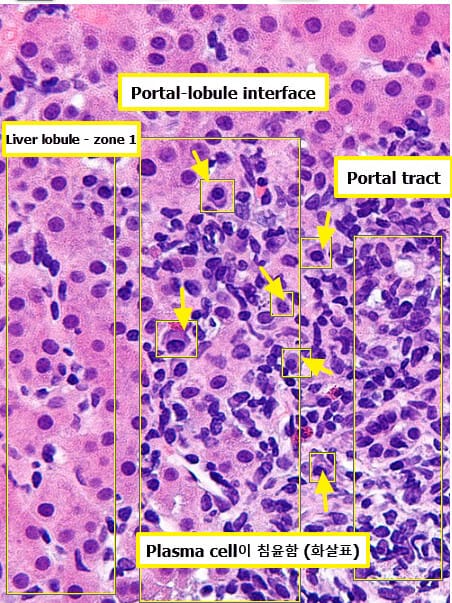

자가면역성 간염 (Autoimmune Hepatitis)
Autoimmune Hepatitis는 면역체계가 간세포를 자가항원으로 인식해 공격하면서 만성 간염을 일으키는 자가면역 질환입니다. 치료하지 않으면 간경변으로 진행할 수 있지만, 조기에 진단하고 면역억제제를 사용하면 대부분 잘 조절됩니다.
면역계가 외부 병원체가 아닌 자신의 간세포를 공격하면서 염증이 생기고, 만성적으로 진행되어 간기능이 저하되는 질환입니다.
| 자가면역성 간염 |
| 🟦 T세포 매개 면역반응이 간세포를 자가항원으로 오인하여 공격하고, 염증과 섬유화를 유발합니다. |
원인
면역 조절 이상에 의해 발생하며, 유전적 소인과 외부 자극(바이러스, 약물 등)이 관련될 수 있습니다.
| 주요 원인 |
| 🔴 면역조절 이상 |
| 자가면역 반응이 조절되지 않아 간세포를 스스로 공격하게 됩니다. |
| 🔴 유전적 소인(HLA-DR3, DR4) |
| 특정 HLA 유형이 자가면역 반응 발생 가능성을 높입니다. |
| 🔴 감염 또는 약물 노출 |
| 바이러스 감염이나 특정 약물이 면역 반응을 유도하는 유발 인자가 될 수 있습니다. |
임상양상
무증상에서 시작되거나 급성 간염처럼 나타날 수 있으며, 시간이 지나면 만성 피로, 황달, 간경변 증상까지 진행될 수 있습니다.
몸이 쉽게 피로하고 식욕이 없으며, 간기능 검사에서 AST/ALT가 지속적으로 상승합니다.
| 증상 및 징후 |
| 🟨 무증상 또는 경미한 피로감 |
| 초기에는 증상이 거의 없거나 피로만 느낍니다. |
| 🟨 오심, 식욕부진 |
| 간염이 진행되면 소화기 증상이 동반될 수 있습니다. |
| 🟨 황달 및 암갈색 소변 |
| 빌리루빈 대사 장애로 인해 피부가 노랗고 소변 색이 진해집니다. |
| 🟨 간경변 증상(복수, 정맥류 출혈 등) |
| 치료하지 않고 방치하면 말기 간질환으로 진행할 수 있습니다. |
진단
혈청 자가항체 검사, 간기능 검사, 조직검사를 종합해 진단하며, 다른 간질환과 감별해야 합니다.
| 진단 방법 |
| 🔵 간기능 검사(AST/ALT, 빌리루빈) |
| ALT, AST가 지속적으로 상승하며, 간세포 손상을 반영합니다. |
| 🔵 자가항체 검사(ANA, ASMA, anti-LKM1 등) |
| 항핵항체(ANA), 평활근항체(ASMA), 간신미세체항체 등이 진단에 도움됩니다. |
| 🔵 IgG 상승 |
| 혈청 면역글로불린 G 수치가 높게 나타날 수 있습니다. |
| 🔵 간 조직검사 |
| 다핵 림프구 침윤, piecemeal necrosis 등 전형적인 조직소견을 보입니다. |
병리학적 소견
| 구분 | 내용 |
|---|---|
| ⭐ Interface hepatitis (piecemeal necrosis) | 간문맥(Portal tract)과 소엽 경계(interface zone)에서 림프구 및 형질세포(Plasma cells)의 염증 세포가 간세포판을 파괴합니다. |
| ⭐ 형질세포(Plasma cell) 침윤 | 문맥삼합부(portal area) 및 소엽(lobule)에 형질세포가 풍부하게 관찰됩니다. AIH의 특징적인 조직학적 소견입니다. |
| 간세포 괴사와 재생 | 소엽 내 중심에서 간세포 괴사, 풍선변성(ballooning), 미세/거대포적 지방변성 등이 동반될 수 있으며 재생구조도 보일 수 있습니다. |
| 로제트 형성(Rosette formation) | 손상된 간세포들이 작은 군집을 이루며 간세포가 별처럼 배열된 모습으로 보입니다. (특이적이진 않지만 동반될 수 있음) |
병리학적 소견
- Portal-lobule Interface에 Plasma cell와 Lymphocyte의 침윤을 보입니다.
- Portal-lobule interface : Portal tract과 Liver lobule 사이
치료
면역억제제를 사용하여 염증을 조절하고 간 손상 진행을 막습니다.
스테로이드를 기본으로 사용하며, 장기적으로는 아자티오프린 등 면역억제제를 병용합니다.
약물 치료
면역 반응을 조절하는 약물을 장기적으로 사용하며, 치료 반응을 관찰하면서 조절합니다.
| 약물 치료 |
| 💊 프레드니솔론(Prednisolone) |
| 스테로이드로, 초기 치료 시 염증을 빠르게 억제합니다. |
| 💊 아자티오프린(Azathioprine) |
| 스테로이드 감량을 돕고 장기 유지치료제로 사용됩니다. |
| 🔴 부작용: 백혈구 감소증, 간독성 |
| 면역억제제로 인해 감염 위험이 높아지고, 간기능 모니터링이 필요합니다. |
예후
치료에 잘 반응하면 간기능을 정상으로 유지할 수 있지만, 치료하지 않으면 간경변으로 진행합니다.
| 예후 |
| 🟧 스테로이드 치료에 대부분 잘 반응하며, 장기 생존율이 높습니다. |
| 🟧 치료를 중단하거나 늦게 시작하면 간경변과 간부전으로 진행할 수 있습니다. |
생활 관리
면역억제제 복용 중에는 감염 예방과 간기능 관리가 중요합니다.
| 생활 관리 수칙 |
| 🟨 정기적인 혈액검사와 간기능 검사 |
| AST/ALT, IgG, 혈구수 등을 주기적으로 확인하여 치료 반응을 평가합니다. |
| 🟨 감염 예방 |
| 면역억제제 복용 시 감염 위험이 높아지므로 개인 위생과 예방접종이 필요합니다. |
| 🟨 간독성 약물 피하기 |
| 간에 부담을 줄 수 있는 약물이나 건강기능식품은 피해야 합니다. |
| 🟨 규칙적인 복약 |
| 약물 복용 중단 시 재발 가능성이 높아 복약 순응도가 매우 중요합니다. |


